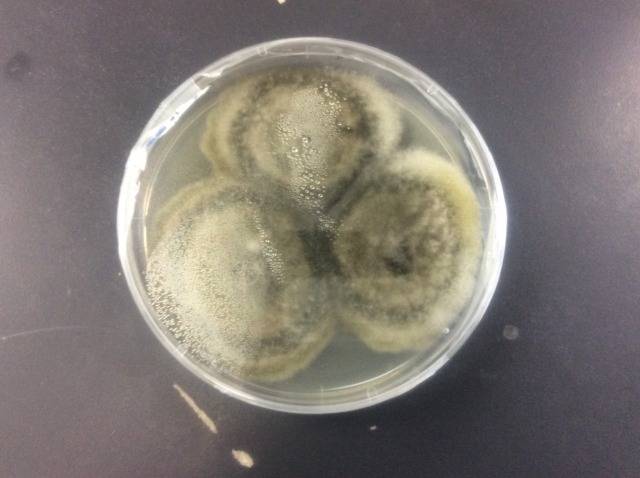

シロアリ点検でカビ発覚! 床下のカビ取り・カビ対策と真菌検査の重要性
2026/02/25
シロアリ点検をきっかけに「床一面のカビ」が見つかるケースが全国で急増しています。普段目にすることのない床下や壁内部の「隠れカビ」は、住まいの寿命を縮め、健康リスクを招く恐れがあります。本記事では、カビバスターズの専門的な調査手法や、地域ごとの発生傾向、正しい対策について網羅的に解説します。
目次
床下の「隠れカビ」という盲点
床下はカビの楽園
床下は住宅の中で最も湿気が溜まりやすく、カビにとって絶好の繁殖場所です。シロアリ業者が点検で潜る際、木材や断熱材を覆い尽くすカビを発見することは珍しくありません。
放置が招く構造劣化
カビを放置すると、木材の腐朽が進み、住宅の耐震性や耐久性が著しく低下します。シロアリ対策と同時にカビ対策を行うことが、家を長持ちさせる秘訣です。
異臭はSOSのサイン
「家の中がなんとなくカビ臭い」と感じる場合、すでに床下で広範囲に繁殖している可能性があります。鼻をつくような臭いは、カビが胞子を放出している証拠です。
専門業者による発見
シロアリ業者は「虫」の専門家ですが、カビの専門家ではありません。指摘を受けたら、まずはカビバスターズのような専門機関に詳細な調査を依頼しましょう。
カビ発生を招く5つの根本原因
地面からの上昇湿気
布基礎の場合、地面から絶えず湿気が上がってきます。ベタ基礎であっても、コンクリートが完全に乾燥するまでには数年かかり、その間の湿気がカビを呼びます。
換気不足の構造的欠陥
床下換気口が塞がっていたり、基礎の形状により空気の淀み(デッドスペース)が生じたりすると、湿気が排出されずカビの温床となります。
配管からの微細な漏水
給排水管からのわずかな水漏れは、シロアリだけでなくカビの主要な原因です。水漏れに気づかないまま数ヶ月経つと、床一面がカビに覆われます。
室内外の激しい温度差
冬場の床下は冷え込みやすく、室内の暖気が床板を通じて冷やされることで結露が発生します。この「床下結露」がカビを急成長させる要因です。
建材自体の高い含水率
新築時の雨濡れや、施工時の乾燥不足により建材が水分を含みすぎている場合、密閉された床下でカビが内部から噴き出すことがあります。
種類でリスクが変わる!
真菌(カビ菌)検査の必要性
見た目では判断不能
「白カビだから大丈夫」という思い込みは危険です。白いカビの中にも、強力なアレルゲンを持つ種や毒素を生成する種が存在するため、科学的な特定が必要です。
微生物対策協会との連携
カビバスターズは一般社団法人微生物対策協会と連携し、高度な培養・同定検査を行います。これにより、そのカビが人体や建物にどの程度危険かを判定します。
胞子の飛散量を数値化
空気中のカビ胞子数を計測することで、床下のカビが居住空間にどの程度侵入しているかを把握できます。これは健康被害を未然に防ぐための重要な指標です。
最適な施工プランの策定
カビの種類によって、使用すべき薬剤や殺菌プロセスが異なります。検査結果に基づいたオーダーメイドの施工を行うことで、無駄のない確実な除去が可能になります。
カビバスターズの多角的な調査
含水率調査で数値を把握
木材の含水率が20%を超えるとカビのリスクが跳ね上がります。専用の計測器を用い、目視では分からない建材内部の水分量を徹底的にチェックします。
負圧検査で空気の流れを
風量計を使い、家全体の空気の流れ(負圧状態)を確認します。外部から湿った空気を吸い込みやすい構造になっていないか、科学的に分析します。
ファイバースコープ調査
壁の内部や天井裏など、解体しなければ見えない場所を小型カメラで調査します。断熱材の裏側で密かに広がるカビを見逃しません。
環境要因の総合分析
温度、湿度、気流、建材の状態をすべてデータ化し、「なぜカビが発生したのか」という根本原因をレポートにまとめ、再発防止策を提案します。
日本全国どこでも危険!地域別のカビ発生傾向
北国の結露型カビ
北海道や東北、北陸地方では、冬場の高い気密性と室内外の温度差による「内部結露」が原因で、壁内や床下にカビが発生しやすくなります。
都市部の高気密住宅
東京、大阪、名古屋などの都市部では、隣家との距離が近く風通しが悪いため、高気密・高断熱住宅のわずかな隙間でカビが繁殖する事例が増えています。
九州・沖縄の高温多湿
福岡や沖縄など、年間を通じて湿度が高い地域では、地面からの湿気が直接的な原因となります。梅雨時期から夏にかけて爆発的にカビが広がります。
盆地特有の滞留湿気
京都や山梨のような盆地では、空気が停滞しやすく湿度が逃げにくい地形的要因があります。こうした地域では、床下換気扇の併用などが有効です。
カビが家族と住まいに与える深刻なダメージ
アレルギー疾患の誘発
カビの胞子を吸い込み続けることで、喘息、鼻炎、アトピー性皮膚炎などの症状が悪化する可能性があります。特に乳幼児や高齢者は注意が必要です。
シロアリ被害の助長
カビが発生している湿った木材は、シロアリが最も好む環境です。カビを放置することは、間接的にシロアリを呼び寄せているのと同じことになります。
資産価値の著しい低下
カビによる汚染や木材の腐食が進んだ家は、売却時の査定に大きく響きます。「カビ臭い家」は買い手がつきにくく、資産としての価値を損ないます。
精神的なストレス
目に見えるカビや消えない臭いは、居住者の精神的なストレスとなります。家がリラックスできる場所ではなくなることは、生活の質を大きく下げます。
MIST工法®による究極のカビ取り
素材を傷めない独自技術
カビバスターズが採用する「MIST工法®」は、強力な擦り洗いを必要としません。建材を傷めず、素材の奥深くまで浸透して根こそぎ殺菌します。
人に優しい安全性
使用する薬剤は安全性が高く、小さなお子様やペットがいるご家庭でも安心して施工いただけます。残留薬品による二次被害の心配もありません。
圧倒的な再発抑制力
カビを除去するだけでなく、抗菌・防カビ処理を施すことで、将来的な発生リスクを大幅に低減します。原因改善とセットで行うことで効果は永続します。
全国どこでも同じ品質
北海道から沖縄まで、カビバスターズのネットワークは全国を網羅しています。どの地域でも、本部直伝の高度な技術による施工が受けられます。
カビは住まいからのSOS!早期検査が家族を守る
まとめ
床下のカビは、住宅の健康状態を示す重要なサインです。シロアリ点検で指摘されたら、それは家を根本から見直す絶好のチャンス。カビバスターズは、真菌検査から高度な除去、再発防止までをワンストップで提供します。大切な家と家族の健康を守るために、まずは現状を知る「検査」から始めてみませんか?
------------------------------------------------------------------------------------------------------------------------
カビ取り・カビ対策専門業者MIST工法カビバスターズ本部
0120-052-127(平日9時から17時)
カビの救急箱
【検査機関】
一般社団法人微生物対策協会
------------------------------------------------------------------------------------------------------------------------